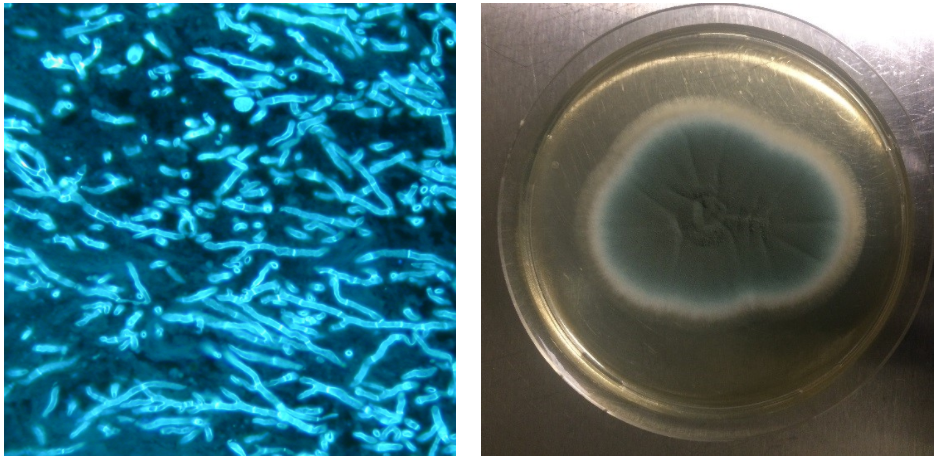
Eloise Ballard

This topic takes on average 55 minutes to read.
There are a number of interactive features in this resource:
 Biology
Biology
 Chemistry
Chemistry
 PSHE / Citizenship studies
PSHE / Citizenship studies
 Science
Science
Tackling antimicrobial resistance requires the help of everyone including members of the public, doctors, the government and the pharmaceutical industry.
Antimicrobial resistance can be tackled in various ways. Some different ways are explained below.
Antimicrobial misuse drives the spread of resistance. A global behaviour change is required to reduce misuse and make a long-term difference.
Public Health England (PHE) started a campaign aiming to improve public awareness and encourage people to use antimicrobials responsibly. More information on the campaign can be found here - Antibiotic Guardian.
It is also important that doctors change prescribing practices to reduce antimicrobial use and ensure that the appropriate antimicrobials are selected. Various apps (eg RxGuidelines app) have been created to help doctors with this.
Current diagnostic tests take more than 48 hours to identify the microorganism and assess its resistance profile. To prevent increased sickness and even patient death, doctors must begin treatment before the test results come back. This can often lead to inappropriate antimicrobial usage.
The ability to identify microbes causing infection rapidly could help reduce inappropriate antimicrobial use. One exciting new technology that could revolutionise diagnosis is the Bruker MALDI Biotyper. This technology uses MALDI-TOF mass spectrometry to generate proteomic fingerprints, which are used to rapidly identify a microbe and its resistance profile. Once an organism has been isolated, this technology can be used to identify the organism in ~30 minutes. This technology could enable the appropriate antimicrobial to be selected more quickly.
Aspergillus fumigatus is the causative agent of invasive aspergillosis (a life threatening fungal lung infection). This infection usually only occurs in immunocompromised patients. Diagnosis of Aspergillus fumigatus infections is difficult. Current diagnostic tests take ~72 hours and often provide false negatives. Sadly, Aspergillus fumigatus infections are frequently only identified during post-mortem examination.
The images below show Aspergillus fumigatus isolated from a lung biopsy. The fungus was identified microscopically (left image) and via growth on a petri dish (right image).
The images above show Aspergillus fumigatus isolated from a lung biopsy. The fungus was identified microscopically (left image) and via growth on a petri dish (right image). Photos by Eloise Ballard.
By preventing the spread of infection, we can reduce the spread of resistance. Improving sanitation in the community and in healthcare settings (eg hospitals) is a simple way of doing this. Something as simple as hand washing can make a huge difference.
Surveillance of resistance levels globally is important. It can provide early warning for potential infection outbreaks, guide changes in governmental policy and allow doctors to make informed decisions on what antimicrobial to prescribe.
Vaccines contain dead, weakened or fragmented pathogens. They present the body with the antigens found on the surface of an active pathogen, or with toxins made by a pathogen, but in a form that cannot cause disease.
Vaccination produces active immunity in people, protecting them from future infection caused by that pathogen. When the majority of a population is vaccinated, the spread of infection is contained. This protects members of the population who cannot be vaccinated (eg elderly people or pregnant women). This is called herd immunity - the animation below explains this idea more.
For herd immunity to be effective, a certain percentage of the community must be vaccinated. This proportion is specific to how infectious the disease is. To provide herd immunity for whooping cough, a disease caused by the bacterium Bordetella pertussis, for example, the World Health Organisation has set the vaccine threshold at 82%. For measles, a highly contagious disease caused by a virus, this threshold was set higher, at 95%1.
Vaccine hesitancy is defined by the World Health Organisation (WHO) as, ‘the reluctance or refusal to vaccinate despite the availability of vaccines’1. It is a complex societal issue that varies in different countries and communities. It is influenced by:
Vaccines are described as ‘victims of their own success’. As most people in the developed world no longer experience regular and devastating disease outbreaks, they think that vaccination is no longer necessary, or more of a risk than the disease it prevents against. This unfortunately gives the disease a chance to return, such as with the 2019 outbreak of measles in the U.S., despite the country having declared the disease eradicated in 2000 2.
The childhood vaccinations that are recommended by governments often requires more than one vaccination to give the body immunity to a disease. Healthcare costs and taking time away from work to get children or pets vaccinated poses an obstacle for some parents, preventing them from being able to vaccinate 3.

Measles symptoms include a hacking cough, a fever and red spots with bluish centres. Complications of measles infections can include making you more vulnerable to other infections, such as encephalitis and pneumonia3, by wiping out your built-up antibodies2.
Vaccines are often described as “victims of their own success”
A lack of trust in vaccines has been around for as long as the technology itself. In 1772, an English Reverend referred to vaccines as ‘diabolical operations’. Lack of knowledge around the causes of sickness meant that infectious diseases were often considered a punishment from God for sin, and vaccines were considered ‘an attempt to oppose God’s punishments upon man for his sins’ 4. More recently, anti-vaccine actions included a paper published by a now discredited British doctor and researcher in 1998. In this paper, which has since been discredited, the measles, mumps and rubella (MMR) vaccine was linked to the development of autism in young children 4. This myth spread to many different parts of the world, resulting in a drop in the MMR vaccination rate. In the UK, for example, vaccination rates dropped from 92% in 1996 to 84% in 2002. This has resulted in several breakouts of measles occurring throughout the world 4.
Combating vaccine hesitancy requires a collaborative effort between doctors, parents, public health officials, governments, the technology sector, and society.
Generally, health workers in communities are the most trusted advisors to support people’s vaccination decisions, and they must be supported to make tools available to them to provide credible, trusted information on vaccines. The WHO has developed specific guides for health workers to help them have conversations with people who are hesitant to get themselves or their children vaccinated. They have also developed the Guide to Tailoring Immunisation programmes (TIP), which aims to:

To improve uptake, it is important to understand why people choose to vaccinate, and several groups have been established to assess these reasons over time. It is also important to address missed opportunities for vaccination – some people may not have been able to be vaccinated as a child but can chose to catch up on these missed vaccinations as an adult.
Finally, it is important to engage with communities, especially those that are particularly at risk of a low vaccination rate 5. Several recent campaigns have aimed to raise the profile and public awareness of the benefit of vaccines. World Immunisation Week, which runs yearly in the last week of April (2019/2020), set up by the United Nations Children’s Fund (UNICEF), is a global campaign. In 2020 the event ran with the theme ‘Vaccines work for All’, with a focus on ‘how vaccines – and the people who develop, deliver and receive them – are heroes by working to protect the health of everyone, everywhere’ 6. The British Society for Immunology campaign, ‘Celebrate Vaccines’, celebrates the role of vaccines in improving global health.
Despite significant research into the discovery of novel antimicrobials, no new classes of antibiotics have been discovered since 1978. For more information on how medicines are developed have a look at - Making medicines.
New antimicrobials are desperately required to treat resistant infections. There are few incentives for pharmaceutical companies to develop new antimicrobial medicines. Possible reasons for this include:
There is great demand for incentives to be provided for pharmaceutical companies developing antimicrobials.
What do you think should be done to give pharmaceutical companies incentive to develop antimicrobial medicines?
Use the links below to find out more information:
More must be done to develop new antibiotics, The Guardian
A plan for new antibiotics, Science
Review on antimicrobial resistance, AMR Review

There are various alternatives to antimicrobial medicines currently under development. Alternative treatments, to which microbes are less likely to develop resistance, would be valuable.
Bacteriophages are natural or synthetic viruses that infect and kill specific bacteria. They do this by injecting their DNA into the bacterial cell. The bacteria then replicates the viral DNA and synthesises new bacteriophages. These new bacteriophages escape the bacteria causing its lysis and death. The antibacterial activity of bacteriophages can be harnessed to treat bacterial infections. The structure of a bacteriophage is shown below.

Lysins are proteins that lyse and kill bacterial cells. A number of studies have shown the potential of lysins to control and treat bacterial infections in humans.
Antibodies bind to specific targets- once bound the target is recognised by the immune system for destruction. Antibodies that recognise microbes can be isolated from patients or synthesised. Antibodies are highly specific- this makes them an attractive therapy.
Antimicrobial peptides are short and generally positively charged peptides. These peptides have the ability to kill microbes directly or indirectly by modifying the immune system. Several antimicrobial peptides are currently in clinical trials as antifungal agents.

e-bug (www.e-bug.eu) is a free educational resource produced by Public Health England for classroom and home use and makes learning about micro-organisms, the spread, prevention and treatment of infection fun and accessible for all students.